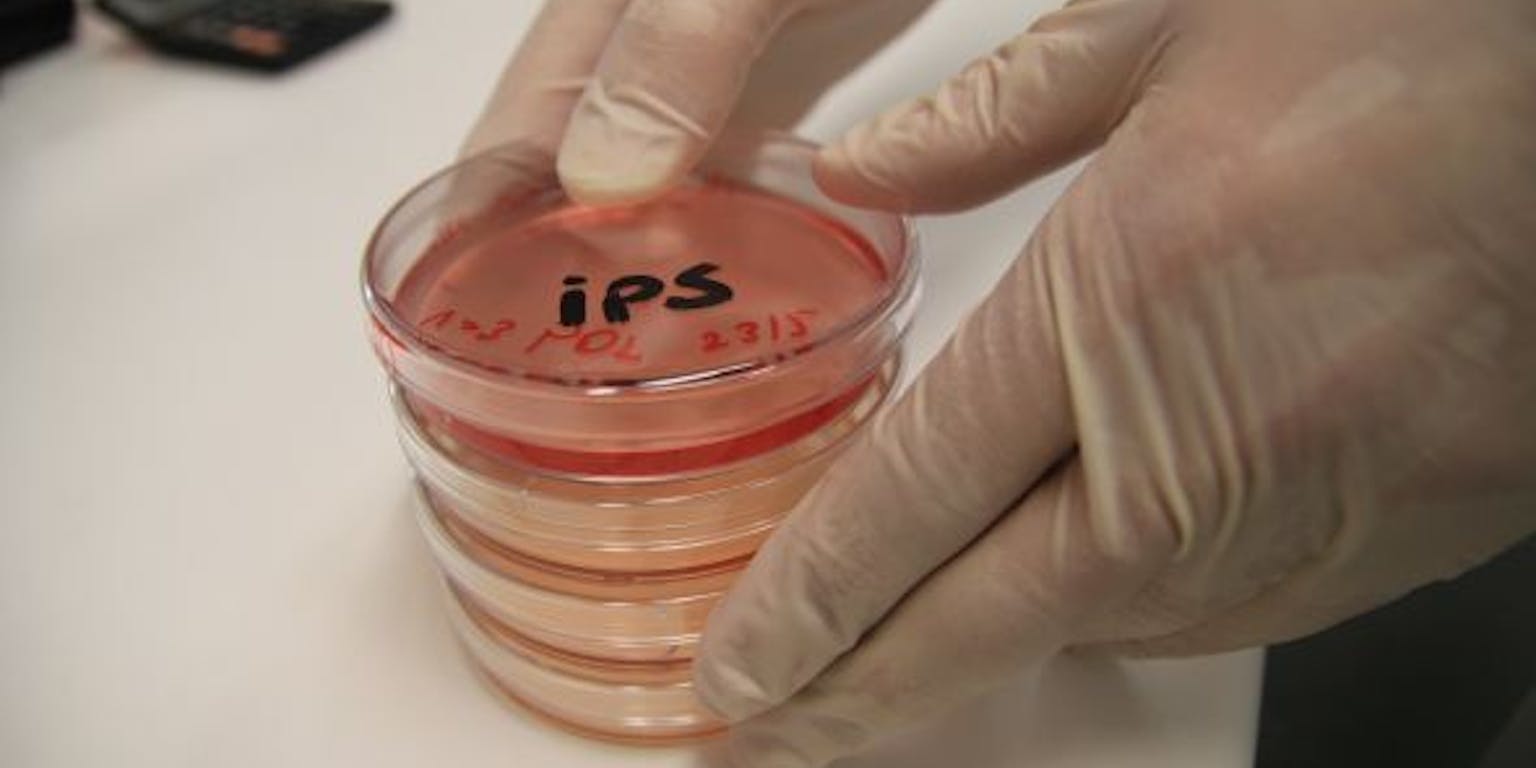

Lichaamseigen stamcellen zijn wellicht de sleutel tot een werkzaam kankervaccin. De stamcellen leren het afweersysteem om tumorcellen te herkennen en aan te vallen. Bij muizen slaat die behandeling goed aan. In de komende twee jaar moet blijken of de stamcellen ook in menselijk weefsel succesvol zijn.
Kanker ontstaat doordat sneldelende, op hol geslagen cellen niet door het afweersysteem worden opgeruimd. De zoektocht naar een kankervaccin is erop gericht om het afweersysteem zo te trainen dat het de tumorcellen wel kan herkennen en aanvallen. Tot nu toe is dat lastig. Iedere tumorcel heeft een unieke combinatie van eiwitten op zijn oppervlakte. Het is haast ondoenlijk om al deze verschillende eiwitten aan het afweersysteem te presenteren.
Tumorcellen afgestoten
De artsen Joseph Wu en Nigel Kooreman hebben daar iets op gevonden. In de afgelopen jaren ontdekten zij dat lichaamseigen stamcellen (iPS-cellen) sterk overeenkomen met tumorcellen. Veel van de eiwitten die tumorcellen op hun oppervlakte dragen, vind je ook terug bij iPS-cellen. Vanuit die waarneming ontstond het idee om iPS-cellen te gebruiken voor de activatie van het afweersysteem tegen kanker.
Kooreman voerde het onderzoek uit aan de Amerikaanse universiteit van Stanford. Hij vaccineerde vier groepen muizen; een controlegroep, een groep die behandeld werd met iPS-cellen, een groep die behandeld werd met een afweerstimulerende stof en een groep die behandeld werd met zowel iPS-cellen als een afweerstimulerende stof. Vervolgens transplanteerde Kooreman borstkankercellen naar de muizen. Alleen in de laatste groep zag hij de tumor bij zeven van de tien dieren volledig afgestoten worden. Twee muizen werden langer geobserveerd. Zij leefden nog een jaar, zonder dat de kanker terugkwam.
Op twee manieren inzetten
Kooreman herhaalde het experiment met huidkankercellen en longkankercellen en zag vergelijkbare resultaten. Hij verwacht dan ook dat een vaccin met iPS-cellen veel, zo niet alle, vormen van kanker kan aanpakken. “De kracht van ons vaccin is dat je een heel groot panel aan oppervlakte-eiwitten aanbiedt”, zegt hij. “Daar zitten waarschijnlijk zelfs eiwitten bij die we nog niet eens kennen. Omdat er zoveel overlap is tussen de eiwitten van iPS-cellen en van tumorcellen, wordt het na vaccinatie voor kanker veel lastiger om het afweersysteem te ontwijken.”
Het vaccin kan op twee manieren worden ingezet. De eerste optie is profylactisch, dus voordat iemand echt kanker heeft. Het is dan wel een uitdaging om te bepalen wanneer je het vaccin geeft. “Het is bekend dat de afweerfunctie bij ouderen vermindert, omdat er minder afweercellen in het bloed circuleren. Je zou met dit vaccin de afweer een boost kunnen geven, bijvoorbeeld bij iedereen vanaf zeventig jaar”, meent Kooreman.
Een tweede optie is dat het vaccin ingezet wordt als iemand al kanker heeft, als aanvulling op bestaande therapie. “Je kunt het vaccin dan gebruiken om bijvoorbeeld na een operatie of chemotherapiebehandeling het afweersysteem te activeren”, legt Kooreman uit. “Op het moment dat iemand naar het ziekenhuis komt voor een eerste behandeling, kun je als arts bloed of huidcellen afnemen om iPS-cellen te kweken. De iPS-cellen zijn dan direct beschikbaar als dat nodig is.”
Testen op menselijk weefsel
Zover is het voorlopig nog niet. “We hebben in de muizenstudie al veel gekeken naar veiligheid. We zagen bijvoorbeeld dat het vaccin specifiek tumorcellen aanvalt en gezonde, lichaamseigen cellen met rust laat. Maar het afweersysteem van de mens is anders dan dat van de muis, dus het is wel zaak dat we nog een keer goed naar de functie en de veiligheid gaan kijken”, zegt Kooreman.
Dit gebeurt in de komende twee jaar. Dan wordt de effectiviteit van het vaccin getest in menselijk weefsel. Kooreman: “Als die tests slagen, kunnen we wellicht de overstap maken naar onderzoek met proefpersonen. De komende twee jaar worden dus heel interessant.”